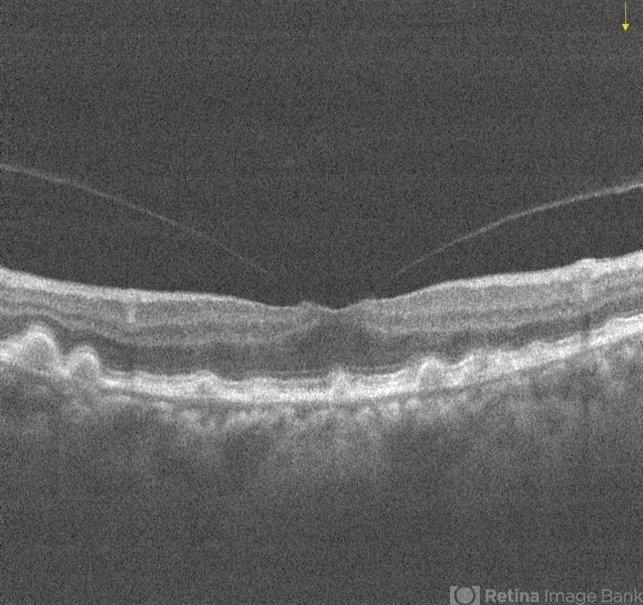

-
 By Ogugua Ndubuisi Okonkwo, MD, FRCS (Edin), FASRS
By Ogugua Ndubuisi Okonkwo, MD, FRCS (Edin), FASRS
Eye Foundation Retina Institute
Co-author(s): Adekunle Hassan MD; Olufemi Oderinlo MD - Uploaded on Feb 7, 2018.
- Last modified by Chayal Patel on Feb 13, 2018.
- Rating
- Appears in
- Miscellaneous
- Condition/keywords
- drusenoid deposit, vitreomacular traction (VMT)
- Photographer
- Oreoluwa, Eye Foundation Retina Institute . Lagos
- Imaging device
- Optical coherence tomography system
- Description
- Left eye OCT of same 73-year-old female showing drusenoid PED and Vitreomacular Adhesion .

Initializing download.
Initializing download.










